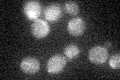
YNL094W
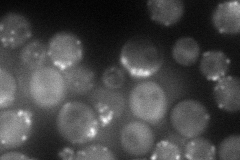
YNL094W
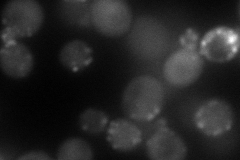
YNL094W
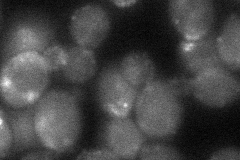
YNL094W
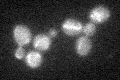
YNL094W
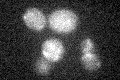
YNL094W

View description
Protein of unknown function, interacts with Rvs161p and Rvs167p; computational analysis of protein-protein interactions in large-scale studies suggests a possible role in actin filament organization
Localization:
Intensity:
Fold change:
Significance:
-
C’ GFP library in SD
cytosol21.58 -
N' NOP1pr-GFP in SD
punctate,bud71.7382 -
N' TEF2pr-mCherry in SD
punctate,bud neck83.5812 -
N' NATIVEpr-GFP in SD

below threshold22.0285 -
N' TEF2pr-VC and Cyto-VN in SD
punctate38.2912 -
C’ GFP library in SD+DTT

cytosolN/AN/ANo -
C’ GFP library in SD+H2O2
cytosol21.831.01No -
C’ GFP library in Starvation Media
cytosol17.650.81No -
C’ GFP library on the background of Pup2-DaMP

cytosol -
C’ GFP library on the background of CCT mutant

cytosol26.91021.24676No
